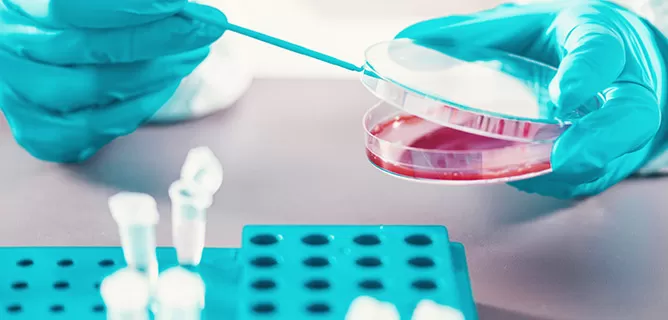
Custom Gene Synthesis

High-accuracy DNA sequences for expressing and mutating potential targets.

Rapid design and delivery of knockdown tools for functional studies.

Optimized guide RNAs with high on-target efficiency.

Expression-Ready constructs tailored for mammalian or microbial systems.

Ensure robust target expression across multiple host systems.
99.5%+ coupling efficiency ensures sequence reliability
Streamlined workflows deliver DNA, RNA, and plasmids in record time.
From single constructs to large-scale libraries.
Empowering over 300,000 customers worldwide.